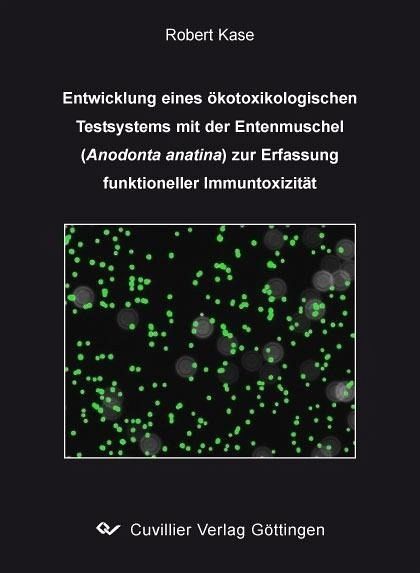

Entwicklung eines ökotoxikologischen Testsystems mit der Entenmuschel (Anodonta anatina) zur Erfassung funktioneller Immuntoxizität (eBook, PDF)
PAYBACK Punkte
0 °P sammeln!
Gegenstand der Untersuchung.
In der vorliegenden Arbeit wurden Grundlagen zur Beurteilung des Immunstatus von Muscheln als Indikatororganismen in aquatischen Ökosystemen und zur Entwicklung eines Testverfahrens auf Immuntoxizität für den Süßwasserbereich erarbeitet.
Methodik als primäre immuntoxikologische Endpunkte wurden die Modulationen der Phagozytoseaktivität sowie der Produktion reaktiver Sauerstoffspezies (Reactive Oxygen Species, ROS) in vitro und in vivo mit Muscheln der Art Anodonta anatina (Entenmuschel) untersucht. Sekundäre Endpunkte waren die Vitalität der Häm...
Gegenstand der Untersuchung.
In der vorliegenden Arbeit wurden Grundlagen zur Beurteilung des Immunstatus von Muscheln als Indikatororganismen in aquatischen Ökosystemen und zur Entwicklung eines Testverfahrens auf Immuntoxizität für den Süßwasserbereich erarbeitet.
Methodik als primäre immuntoxikologische Endpunkte wurden die Modulationen der Phagozytoseaktivität sowie der Produktion reaktiver Sauerstoffspezies (Reactive Oxygen Species, ROS) in vitro und in vivo mit Muscheln der Art Anodonta anatina (Entenmuschel) untersucht. Sekundäre Endpunkte waren die Vitalität der Hämozyten und Veränderungen der vitalen Hämozytendichte. Zur Erfassung der Messparameter wurden durchflusszytometrsiche, photometrische sowie fluorimetrische Methoden etabliert und validiert.
Dieser Download kann aus rechtlichen Gründen nur mit Rechnungsadresse in A, B, BG, CY, CZ, D, DK, EW, E, FIN, F, GR, HR, H, IRL, I, LT, L, LR, M, NL, PL, P, R, S, SLO, SK ausgeliefert werden.